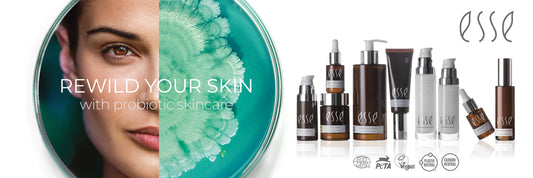

Nyheter

Hud och solning – hur mycket sol är lagom?
I det här inlägget kommer vi att titta på varför solkräm är så viktigt och hur det kan bidra till att bevara din hudhälsa. Vi påminns ständigt om riskerna med...
Hud och solning – hur mycket sol är lagom?
I det här inlägget kommer vi att titta på varför solkräm är så viktigt och hur det kan bidra till att bevara din hudhälsa. Vi påminns ständigt om riskerna med...

Derma Westby fyller år 🥂 🎈
Stort tack till alla er som kom och firade Derma Westby idag 🥂 🎈 Visa detta inlägg på Instagram Ett inlägg delat av Derma Westby (@dermawestby)
Derma Westby fyller år 🥂 🎈
Stort tack till alla er som kom och firade Derma Westby idag 🥂 🎈 Visa detta inlägg på Instagram Ett inlägg delat av Derma Westby (@dermawestby)
Varför probiotisk hudvård?
Probiotika, kända för sina hälsofrämjande egenskaper i mag-tarmkanalen, spelar även en viktig roll i hudens ekosystem. Här är några anledningar till varför man bör överväga probiotisk hudvård: Förstärker hudens barriärfunktion...
Varför probiotisk hudvård?
Probiotika, kända för sina hälsofrämjande egenskaper i mag-tarmkanalen, spelar även en viktig roll i hudens ekosystem. Här är några anledningar till varför man bör överväga probiotisk hudvård: Förstärker hudens barriärfunktion...